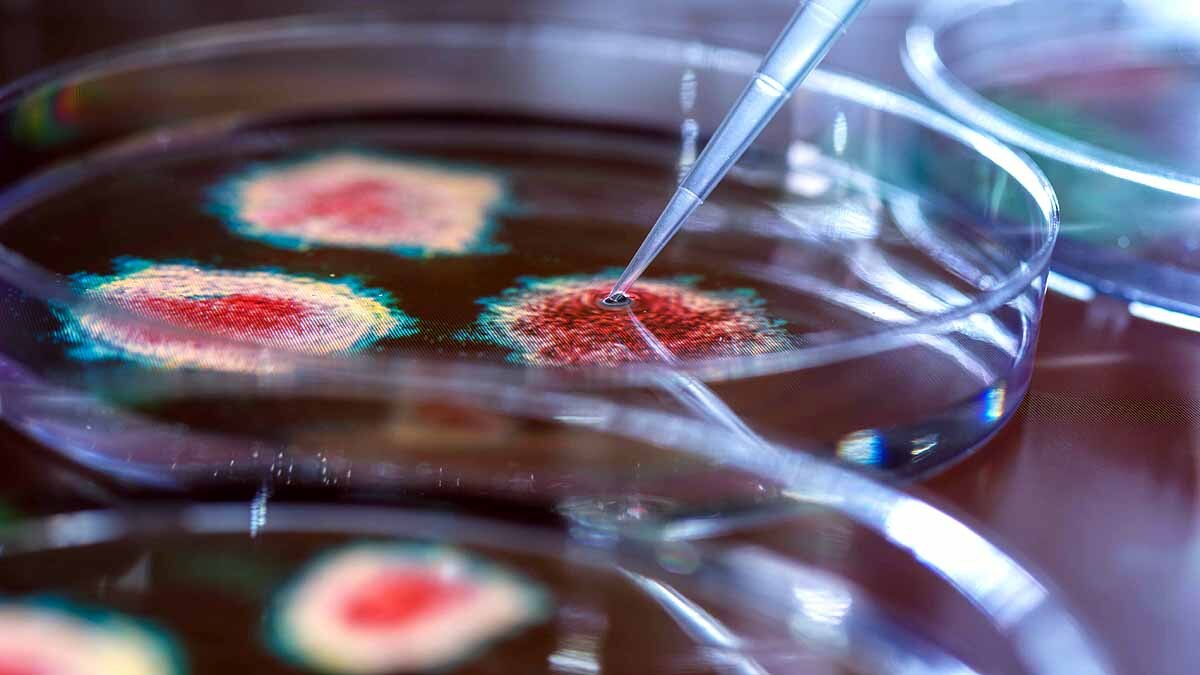
Weight of All Covid-19 Virus

पूरी दुनिया में फैले Covid-19 वायरस का कुल वजन कितना है? नई स्टडी में खुलासा
पूरी दुनिया में कोरोना वायरस फैला हुआ है. करोड़ों लोग संक्रमित हैं. अगर इन सारे कोरोना वायरस को एक जगह पर जमा करके उनका वजन पता किया जाए तो कितना होगा? वैज्ञानिकों ने दुनिया में मौजूद सारे कोरोना वायरस के वजन का पता लगाया है. इससे यह पता चलता है कि पूरी दुनिया में किसी तरह के जैविक हथियार से हमला करने के लिए कितना रसायन या बैक्टीरिया या वायरस चाहिए होगा. वैज्ञानिकों ने अपनी नई स्टडी में बताया कि यह एक सेब से लेकर एक नवजात बच्चे के वजन के बीच में है. (फोटोःगेटी)
इजरायल के वीजमैन इंस्टीट्यूट ऑफ साइंस के वैज्ञानिकों ने यह स्टडी की है. उन्होंने दुनिया में कोरोना वायरस संक्रमित लोगों के सैंपलों से यह गणना की है. कोरोना वायरस ने महामारी के समय में किसी भी जगह पर एक मौके पर 10 लाख से 1 करोड़ लोगों को संक्रमित किया है. इस हिसाब से वैज्ञानिकों ने पूरी दुनिया में फैले कोरोना वायरस के वजन की गणना की है. (फोटोःगेटी)
वीजमैन इंस्टीट्यूट ऑफ साइंस में डिपार्टमेंट ऑफ प्लांट एंड एनवॉयरमेंटल साइंसेस के प्रोफेसर और इस स्टडी के सीनियर रिसर्चर रॉन मिलो ने कहा कि पूरी दुनिया में फैले कोरोना वायरस का वजन 0.1 से लेकर 10 किलोग्राम तक वजन हो सकता है. कम वजन वाली संख्या का मतलब ये नहीं है कि वो खतरनाक नहीं है. (फोटोःगेटी)
रॉन ने बताया कि हम वायरस के सूक्ष्मतम वजन की बात कर रहे हैं. कम से कम वजन के वायरस भी दुनिया में तबाही मचाने के लिए काफी हैं. इस समय कोरोना वायरस की वजह से पूरी दुनिया में 17.3 करोड़ से ज्यादा लोग संक्रमित हैं. जबकि, 37 लाख से ज्यादा लोग मारे जा चुके हैं. रॉन ने बताया कि हमने यह गणना कैसे की. उन्होंने पहले बंदरों पर कोविड-19 वायरस के संक्रमण का दर निकाला, वह भी उस समय जब उसे सबसे ज्यादा संक्रमण था. यानी शरीर में सबसे ज्यादा कोरोना वायरस के कण थे. (फोटोःगेटी)
रॉन और उनकी टीम ने फेफड़ों, टॉन्सिल, लिंफ नोड्स और पाचन प्रणाली में कोरोनावायरस के मात्रा को नापा. इसके बाद उन्होंने कोरोना वायरस के कणों की प्रति ग्राम ऊतक के हिसाब से गणना की. इसके बाद उसे इंसान के ऊतकों के वजन से तुलना की. जिससे इंसानों में फैले कोरोना वायरस के कणों का पूरा वजन निकल कर आया है. इसमें कम वजन के वायरस का मतलब है कि उस समय कोरोना केस कम थे. 10 किलोग्राम वजन का मतलब है जब दुनिया में कोरोना वायरस पीक पर था. (फोटोःगेटी)
Scientists Have Calculated The Weight of All The SARS-CoV-2 in The Worldhttps://t.co/jNzKIynWCi
— ScienceAlert (@ScienceAlert) June 9, 2021
पिछली गणना में कोरोना वायरस के व्यास के आधार पर एक वायरस कण का वजन 1 फीमैटोग्राम था. हर वायरस कण के मास की इंसानों के अंदर मौजूदगी के अधार पर गणना करने पर यह 1 माइक्रोग्राम से 10 माइक्रोग्राम के बीच आ रहा था. यानी जब कोरोना वायरस पीक पर था तब 10 माइक्रोग्राम और जब सबसे कम था तब 1 माइक्रोग्राम वजन था. इन आंकड़ों का जोड़ घटाना करने के बाद वैज्ञानिकों ने दुनिया भर में संक्रमित सभी लोगों का औसत वजन निकाला. उसके बाद इस आंकड़े के अनुसार कोरोना वायरस के वजन की गणना की. (फोटोःगेटी)
रॉन और उनके साथी सेंडर ने बताया कि हमने सिर्फ यही काम नहीं किया. अपने आंकड़ों की सटीकता जांचने के लिए हमने यह भी गणना की शरीर की कितनी कोशिकाएं कोरोना वायरस से संक्रमित हैं. एक कोशिका में कितने वायरस मौजूद है. उसके बाद उनकी पूरी संख्या को 1 फीमैटोग्राम वजन से गुणा कर दिया. इससे भी हमारे आंकड़े पुख्ता हुए. इससे साथ में ये भी पता चला कि हमारे शरीर में कोरोना वायरस कितनी तेजी से फैलता है. (फोटोःगेटी)
रॉन की टीम ने यह भी पता किया एक वायरस एक समय में एक शख्स के शरीर में औसत कितने प्रकार के म्यूटेशन कर सकता है. इसके लिए वैज्ञानिकों ने यह देखा कि इकलौता न्यूक्लियोटाइड कितनी बार म्यूटेट होता है. फिर यह देखा कि वायरस एक इंसान के शरीर में अपनी कितनी कॉपी बनाता है. उसके बाद कॉपी की संख्या और न्यूक्लियोटाइड के म्यूटेशन की संख्या को आपस में गुणा कर दिया गया. जिससे कितनी बार म्यूटेट होता है वायरस, यह पता चल गया. (फोटोःगेटी)
रॉन और उनकी टीम को इस प्रक्रिया से यह पता चल गया कि कोरोना से संक्रमित एक इंसान के शरीर में वायरस का म्यूटेशन 0.1 से एक बार तक हो रहा है. ऐसा संक्रमण होने के 4 से 5 दिन बाद होता है. अगर इंसान महीना भर से ज्यादा बीमार रहता है तो एक महीने के अंदर कोरोना वायरस शरीर के अंदर करीब 3 बार म्यूटेट करता है. जिससे कोरोना वायरस के एवोल्यूशन रेट का पता चलता है. (फोटोःगेटी)
सिर्फ इतना ही नहीं, इंसान के शरीर में कोरोना वायरस के कणों में काफी विभिन्नता भी देखने को मिली है. रॉन और उनकी टीम ने देखा कि एक इंसान के शरीर में कोरोना वायरस पांच से छह बार विभिन्नता लेकर आता है. इसका मतलब ये है कि कुछ गंभीर रूप से बीमार लोगों के शरीर में यह बदलाव लाखों बार हुआ होगा. रॉन मिलो ने कहा कि मुझे पता है कि जिन लोगों के शरीर में कोरोना वायरस के कणों की संख्या कम है, वो कम लोगों को संक्रमित करते हैं. या फिर नहीं करते हैं. (फोटोःगेटी)
रॉन ने बताया कि ये जरूरी नहीं कि सुपरस्प्रेडर्स के शरीर में कोरोनावायरस के कणों की संख्या ज्यादा ही हो. यह निर्भर करता है कि वायरस के वैरिएंट, उसकी क्षमता और अन्य बायोलॉजिकल वजहों पर. कई बार कम वायरस वाले लोग भी सुपरस्प्रेडर बन सकते हैं. इसके पीछे सामाजिक वजहें भी होती हैं. जैसे- उक्त इंसान कितने लोगों से मिलता है. क्या वह बड़ी सभाओं में जाता है. (फोटोःगेटी)
रॉन मिलो ने कहा कि हमारे रिसर्च से हो सकता है कि दुनियाभर के वैज्ञानिकों को कोरोना वायरस से संबंधित जांच-पड़ताल में मदद मिले. हमारी स्टडी की रिपोर्ट प्रोसीडिंग्स ऑफ द नेशनल एकेडमी ऑफ साइंसेस (PNAS) में 3 जून को प्रकाशित हुई है. (फोटोःगेटी)